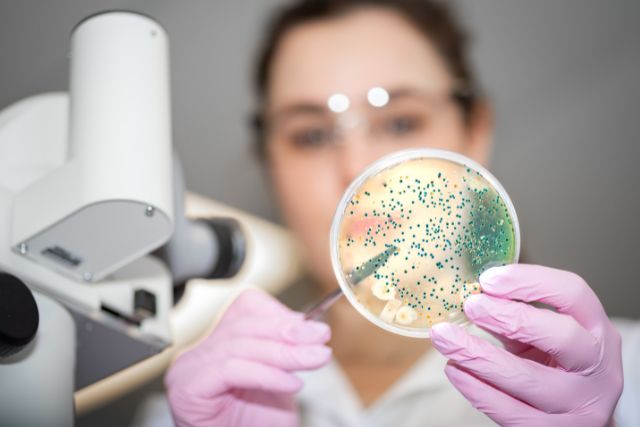
Das Hautmikrobiom: Grundstein für eine gesunde Haut

article.title
Das Hautmikrobiom
Grundstein für eine gesunde Haut
Hast du ein Konto?
Logge dich ein, damit es beim Checkout schneller geht.
€0,00 EUR
GRATIS VERSAND AB 50,- EUR (D)

Grundstein für eine gesunde Haut

Autorin: Maren Kemper
Zuletzt bearbeitet: 11.12.2024
Auf unserer Haut, die ungefähr eine Oberfläche von zwei Quadratmeter hat, leben Milliarden von Mikroben, bestehend aus Bakterien, Pilzen und noch einige anderen Mikroben. Sie siedeln direkt nach Deiner Geburt an und nennen Deine Haut ihr Zuhause.
Forscher sind immer mehr davon überzeugt, dass unsere "Mitbewohner" für unsere Gesundheit entscheidend ist.
Die Gesamtheit aller Mikroben auf der Haut werden als Hautmikrobiom bezeichnet. Befindet sich das Hautmikrobiomim Gleichgewicht, trägt es zum Strahlen der Haut bei, denn es hält den pH-Wert stabil und bildet eine Schutzbarriere, um krankmachende Erreger fernzuhalten. Erstaunlicherweise stehen laut neusten Erkenntnissen die Mikroben unserer Haut mit denen unseres Darms in enger Verbindung!
Das Hautmikrobiom spielt eine entscheidende Rolle für die Gesundheit unserer Haut. Ein gestörtes Hautmikrobiom kann zu verschiedenen Auswirkungen auf die Hautgesundheit führen.
Wenn das Gleichgewicht des Hautmikrobioms gestört ist, kann dies zu verschiedenen Problemen führen. Eine gestörte Hautflora kann dazu führen, dass schädliche Mikroorganismen wie pathogene Bakterien oder Pilze überhandnehmen und die schützende Funktion der Haut beeinträchtigen. Dadurch können Hautirritationen, Entzündungen, Rötungen und Juckreiz auftreten. Ein gestörtes Hautmikrobiom kann auch das Auftreten von Hauterkrankungen begünstigen und den Heilungsprozess verzögern.
Die Forschung hat gezeigt, dass das Hautmikrobiom eine wichtige Rolle bei der Entstehung und dem Verlauf von Hauterkrankungen spielt. Bei bestimmten Hauterkrankungen wie Akne, Ekzemen oder Rosacea wurde ein Ungleichgewicht im Hautmikrobiom festgestellt. Dies deutet darauf hin, dass eine gezielte Pflege des Hautmikrobioms bei der Behandlung und Vorbeugung von Hauterkrankungen helfen kann. Durch die Stärkung der nützlichen Mikroorganismen und die Unterdrückung der schädlichen Bakterien oder Pilze kann das Hautmikrobiom wieder ins Gleichgewicht gebracht werden und die Hautgesundheit verbessern.
Die Produkte, die zur Hautpflege verwendet werden, können die Balance dieser Mini-Bewohner beeinflussen.
Seit langem ist bekannt, dass die Haut einen natürlichen Schutzschild hat, der einen leicht sauren pH-Wert hat. Produkte mit einem pH-Wert von 5,5 können diesen Schutzschild stärken.
Das Haut-Ökosystem kann durch falsche Pflege, Umweltfaktoren, aber auch Stress und falsche Ernährung aus dem Gleichgewicht geraten und es kann dadurch zu einer vorzeitigen Hautalterung und Hauterkrankungen kommen.
Für eine Pflege, die von innen über die Darmflora wirkt, gibt es unser Skin Glow als Nahrungsergänzungsmittel.
Die Gemeinschaft der Mikroorganismen auf Deiner Haut ist entscheidend für Deine allgemeine Hautgesundheit. Sie helfen dabei, Deine Haut stark und widerstandsfähig gegen äußere negative Einflüsse zu machen.
Unser Darmmikrobioms mit seinen Darmbakterien ist für unsere allgemeine Gesundheit unsere mentale Verfassung wie auch unser Immunsystem wichtig. Ähnlich wie die gute Gemeinschaft auf unserer Haut, hilft auch die in unserem Darm, uns gesund zu halten. Nicht nur der Darm, sondern auch die Haut ist voller guter Bakterien und Pilze, die als Teil der ersten Verteidigungslinie gegen schädliche Eindringlinge dienen. Erstaunlicherweise gibt es mittlerweilen Studien, die zeigen, dass sich das Hautmikrobiom und das Darmmikrobiom in einem ständigen Austausch befinden und sich auch gegenseitig beeinflussen.
Info:
Wenige wissen, dass der menschliche Körper aus mehr mikrobiellen Zellen als menschlichen Zellen besteht. Diese Mikroben besiedeln die Haut und den Darm und erfüllen eine Vielzahl von lebenswichtigen Funktionen. Sie spielen eine entscheidende Rolle bei der Verdauung von Nahrung und bieten Schutz vor Krankheitserregern. Ein ausgewogenes Mikrobiom, die Gemeinschaft dieser Mikroorganismen, ist essentiell für die Aufrechterhaltung von Gesundheit und Wohlbefinden. Eine harmonische Mikrobengemeinschaft unterstützt nicht nur die körpereigenen Abwehrmechanismen, sondern trägt auch wesentlich zur allgemeinen Fitness und zum Wohlbefinden bei.
Solange wir uns in dem schützenden Körper unserer Mütter befinden, ist unsere Haut noch fast unbesiedelt – kaum Bakterien weit und breit. Doch das ändert sich mit der Geburt! Kommen wir zur Welt, so nehmen wir bei der Reise durch den Geburtskanal bereits viele Bakterien auf, die dann direkt damit beginnen unsere Haut zu besiedeln.
Diese ersten "Mitbewohner" sind wichtig, weil sie das Immunsystem trainieren und uns gegen negative Keime stärken.
In verschiedenen Studien wurde gezeigt, dass Kinder, die per Kaiserschnitt zur Welt kamen und somit mit mit den wichtigen Keimer ihrer Mutter nicht in Berührung kamen ein erhöhtes Risiko von Krankheiten wie Asthma, Allergien und Übergewicht aufwiesen (5).
Hier findest Du eine weitere interessante Studie über die frühe Kolonisation mit Mikroorganismen.
Das Hautmikrobiom hat viele Aufgaben. Es kümmert sich um die Gesundheit der Haut, in dem es z.B für den richtigen pH-Wert sorgt und bildet so eine Art Schutzwall gegen pathogene, also krankmachende Keime.
Hautprobleme wie Neurodermitis können auftreten, weil beispielsweise das Hautmikrobiom und der pH-Wert aus der Balance geraten sind.
Ein gut funktionierendes Hautmikrobiom sorgt effektiv dafür, dass schlechte Keime abzuwehren.
Verschiedene Dinge, die Dein Haut-Ökosystem durcheinanderbringen können:
Auch einige Krankheiten, die in der Familie liegen, können das Mikrobiom beeinflussen.
Außerdem können falsche Hautpflegeprodukte oder eine übermäßige Hygiene die guten Bakterien auf deiner Haut angreifen und das Ökosystem der Haut aus dem Gleichgewicht bringen. Dadurch wird Deine Haut empfindlicher und kann leichter von krankmachenden Keimen angegriffen werden. Mehr dazu in dieser Forschungsarbeit.
Hier kannst Du mehr über Darmbakterien, Probiotika und deren Einfluss auf die Haut erfahren.
Die Erforschung des Hautmikrobioms ist ein aufregendes und sich ständig weiterentwickelndes Gebiet. Aktuelle Forschungsergebnisse haben bereits wichtige Erkenntnisse über die Rolle des Hautmikrobioms bei der Hautgesundheit geliefert.
In den letzten Jahren haben Studien gezeigt, dass das Hautmikrobiom eine entscheidende Rolle bei der Aufrechterhaltung einer gesunden Haut spielt. Es wurde festgestellt, dass bestimmte Bakterienstämme auf der Haut eine Schutzbarriere bilden können, die das Eindringen von schädlichen Mikroben verhindert.
Des Weiteren wurde entdeckt, dass das Hautmikrobiom eng mit dem Darmmikrobiom interagiert. Über das Darmmikrobiom hat es eine enge Verbindung mit dem Immunsystem. Es unterstützt die Immunabwehr, indem es als Kommunikationsschnittstelle zwischen den Mikroorganismen und den Immunzellen fungiert.
In der Forschung werden auch potenzielle therapeutische Anwendungen von Probiotika und Präbiotika für das Hautmikrobiom untersucht.
Es gibt Hinweise darauf, dass die gezielte Anwendung von probiotischen und präbiotischen Substanzen auf der Haut das Gleichgewicht des Mikrobioms wiederherstellen und bestimmte Hautzustände verbessern kann.
Probiotika sind lebende Mikroorganismen, die einen positiven Einfluss auf die Gesundheit haben. Sie können helfen, die schützende Hautbarriere zu stärken und Entzündungen zu reduzieren. Präbiotika sind Stoffe, die das Wachstum bestimmter nützlicher Bakterien auf der Haut fördern können.
Die Entwicklung von Produkten, die probiotische und präbiotische Inhaltsstoffe enthalten, zeigen besonders vielversprechende Ergebnisse. Solche Kombinationen werden als Synbiotika bezeichnet. Diese Produkte können dazu beitragen, das Hautmikrobiom zu unterstützen und Hautprobleme zu verbessern.
Das Hautmikrobiom, eine vielfältige Gemeinschaft von Mikroorganismen auf der Haut, spielt eine entscheidende Rolle für die Hautgesundheit und das Immunsystem.
Ein ausgewogenes Hautmikrobiom, das durch Faktoren wie Stress, Medikamente und Hautpflegeprodukte beeinflusst wird, unterstützt einen idealen pH-Wert und bildet eine schützende Barriere gegen Krankheitserreger.
Schon bei der Geburt beginnt die Besiedelung der Haut mit Mikroorganismen, die für die Entwicklung des Immunsystems wesentlich ist.
Es besteht eine enge Verbindung zwischen der Haut- und Darmgesundheit, wobei die Darmflora ebenfalls die Haut beeinflusst.
Ein Ungleichgewicht im Hautmikrobiom kann zu Hautproblemen wie Irritationen, Entzündungen und verschiedenen Hauterkrankungen führen.
Die Pflege des Hautmikrobioms ist daher entscheidend für die allgemeine Hautgesundheit.
Die Forschung deutet darauf hin, dass Probiotika und Präbiotika das Hautmikrobiom positiv beeinflussen können, indem sie die Hautbarriere stärken und Entzündungen reduzieren.
Produkte wie Skin Glow, die probiotische und präbiotische Inhaltsstoffe enthalten, versprechen die Unterstützung des Hautmikrobioms und die Verbesserung der Hautgesundheit.
Mikrobiom als natürlicher Schutzfaktor Delivery mode and gut microbial changes correlate with an increased risk of childhood asthma
Die Rolle des Darmmikrobioms bei chronischen Krankheiten: Eine narrative Übersichtsarbeit
Pro- und PräbiotikaThe Relation of pH and Skin Cleansing
Der Artikel dient lediglich der Informationsvermittlung in Bezug auf Probiotika und soll nicht als medizinische Empfehlung oder als Ersatz für professionelle medizinische Beratung oder Behandlung interpretiert werden.


Akazienfasern
Wie der Kauf von Akazienfasern Deine Darmgesundheit – und mehr – fördern kann Die Basis für Balan...


Akazienfasern + Dailys
Darmgesundheit & mehr – Dein Bundle für Balance mit Probiotika & Akazienfasern Ganzheitl...


Dailys 3-Monat
Wie der Kauf von Probiotika-Kapseln Dein Immunsystem, Deinen Stoffwechsel und Deine Hautgesundhe...


Dailys 2-Monats-Nachfüllpackung
Wie der Kauf von Probiotika-Kapseln Dein Immunsystem, Deinen Stoffwechsel und Deine Hautgesundhe...


Daily's
Wie der Kauf von Probiotika-Kapseln Dein Immunsystem, Deinen Stoffwechsel und Deine Hautgesundhe...
